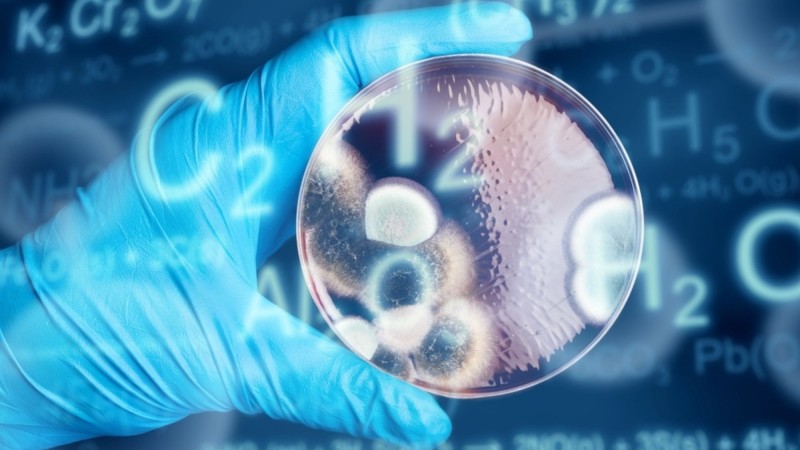

Дэлхийн эдийн засгийн форумаас эрхлэн гаргадаг Дэлхийн тойм (WEFGAC) судалгаагаар саяхан ирэх арван жилд биеллээ олох технологийн хэд хэдэн дэвшилт санааг танилцууллаа. Тэдгээрээс дараах арван бүтээлийг ажиглагчид хамгийн ойрын хугацаанд худалдаанд гарч, бүх нийтийн хэрэглээнд нэвтрэх магадлалтай хэмээн үзжээ.
Биедээ шууд өмсөж болох, эсвэл хувцсан дээрээ давхарлаж өмссөн ч “ажиллах” чадвартай “ухаалаг” төхөөрөмжүүд нь эзнийхээ бухимдал, зүрхний цохилт, даралт зэргийг байнга хянаж, мэдээлж байх юм. Энэ нь зүрхний шигдээс, таталт зэрэг гэнэтийн өвчнөөс сэргийлнэ.
Наножуулсан нүүрстөрөгч бүхий түлш нь одоогийн автомашинуудын хэрэглэдэг шатахуунаас ялгардаг нүүрстөрөгчөөс 40 хувиар бага хор агуулна. Энэ нь байгаль орчны бохирдлыг бууруулаад зогсохгүй эдийн засагт ч хэмнэлттэй юм.
Арабын хойг дахь хөгжингүй орнууд далай тэнгисийн усыг давсгүйжүүлэх аргыг сүүлийн жилүүдэд боловсруулж, ундны цэвэр ус гаргаж авчээ. Энэ аргыг бохир уснаас ашигтай эрдэс бодис ялгаж авахад ашиглахаар туршилт хийж байна. Энэ нь амжилттай болбол цаашдаа хот суурин газрын бохир усанд багагүй хэмжээгээр агуулагддаг гэх олон төрлийн металлыг ялгаж авч болох юм.
Өдгөө дэлхийн ихэнх хэсэгт эрчим хүчний шон, утаснууд зөвхөн дамжуулагчийн үүрэг гүйцэтгэдэг. Харин эх үүсвэрээс нь эрчим хүч ялгарахаа болилоо гэхэд тэдгээр дамжуулагч эрчим хүчний хоёрдогч эх үүсвэр байх боломжийг судлаачид эрэлхийлж байна. Эхний туршилтууд амжилттай болсон бөгөөд нарны болон салхин цахилгаан станцын дамжуулагч утаснуудыг эхний ээлжинд эрчим хүч хуримтлуулагч болгох боломжтой аж.
Японы эрдэмтдийн бүтээж байгаа гэх бичил силикон нано утас бүхий зай нь цэнэгээ одоогийн энгийн хуруу зайнуудаас гурав дахин удаан барих юм.
Гурван хэмжээст дүрс бичлэгийг агаарт “хий” дэлгэц үүсгэн үзэх боломж ойртсоор байна. Хоёр хэмжээст зургуудыг үл баригдагч гэрлэн дэлгэц дээр үзэх туршилт амжилттай болсныг зарласан Английн эрдэмтэд энэ оны сүүлчээр гурван хэмжээст дүрс бичлэгийг агаарт үзүүлэхээ мэдэгдээд байна.
Америк эрдэмтдийн танилцуулсан “Хүний микробиом 2012” хэмээх төсөл хүний бие махбодийг эсийн түвшинд судлах анхны томоохон судалгааны бүтээл болжээ. Харин энэ судалгаанд үндэслэн, хүний микробиом эмчилгээний технологийг эрдэмтэд боловсруулж байна. Энэ нь хүнийг ямар өвчин эмгэг тусах магадлалтайг урьдаас олж тогтооход тусална.
РНХ нь ДНХ-тай адил уургийн нийлэгжилт, генийн мэдээлэл дамжуулах зэрэгт онцгой үүрэгтэй юм. Тиймээс РНХ-ийн бүтэц, өөрчлөлтөд тулгуурлан бүтээсэн “ухаалаг” эм бүтээхээр мэргэжилтнүүд ажиллаж байна. Энэ нь тухайн хүний удам зүйг судалсны дүнд бүтээгдсэн тул зөвхөн нэг л хүнд тусгайлан зориулагдсан эм болох юм байна.
Австрийн судлаачид хүний сэтгэл зүйг алсын зайнаас автоматаар тодорхойлох төхөөрөмж бүтээхээр ажиллаж байна. Энэ нь өвчний оношлогоо, гэмт хэргийн мөрдлөгө зэрэгт ахиц дэвшил авчирна.
Тархины эд эсийн идэвхжилийг орчин цагийн компьютер мэдэрдэг нь батлагдсан. Энэ дэвшлийг ашиглан, хөгжлийн бэрхшээлтэй болон компьютерийн өмнө байнга суух боломжгүй хүмүүсийг цахим сүлжээнд холбох боломж бий.